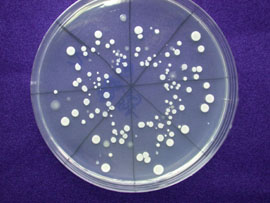
液化澱粉芽孢桿菌菌種(TCB428)純菌培養圖。

55-13 開發新型生物性堆肥之液化澱粉芽孢桿菌菌種(TCB428)
開發新型生物性堆肥之液化澱粉芽孢桿菌菌種(TCB428)
文圖/ 蔡宜峰、陳俊位
產品特性之介紹:
液化澱粉芽孢桿菌菌種(TCB428)是屬於枯草桿菌(Bacillus sp.)之一種,也是台中區農業改良場從農田土壤篩選出的新型本土菌種之一。本菌種具有快速分解含纖維素成分有機質之功能,並具有耐中高溫 (50~65℃)特性,可以促進堆肥材料分解,增進堆肥腐熟。因此,本菌種頗適合應用在堆肥製作上。在堆肥製作時,先調配適當的有機材料種類及用量,以堆 肥材料碳氮比介於25~35間為最佳,再配合接種適量的液化澱粉芽孢桿菌菌種(TCB428)及調整水份含量至60%。爾後堆肥溫度可以於數日內,快速提 高至60℃以上,且堆肥化過程中的臭味也明顯降低,腐熟時程估計可提早3~5日,堆肥成品外觀顏色較深黑褐且鬆軟,腐熟堆肥的養分含量穩定,品質優良。
授權廠商:
福壽實業股份有限公司於95年3月與台中區農業改良場簽署「製造生物性堆肥之液化澱粉芽孢桿菌菌種(TCB428)」專屬技術移轉合約。本產品採用500公克鋁箔包裝,福壽實業股份有限公司設於台中縣沙鹿鎮,電話為(04) 26350539。
| 圖片 | 圖片說明 |
|---|---|
![]() |
利用液化澱粉芽孢桿菌菌種(TCB428)製造堆肥現場之一。 |
![]() |
利用液化澱粉芽孢桿菌菌種(TCB428)製造堆肥現場之二。 |
![]() |
液化澱粉芽孢桿菌菌種(TCB428)純菌培養圖。 |
![]() |
利用液化澱粉芽孢桿菌菌種(TCB428)製造堆肥成品。 |
![]() |
液化澱粉芽孢桿菌菌種(TCB428)製造堆肥產品使用於葡萄栽培現況。 |
![]() |
液化澱粉芽孢桿菌菌種(TCB428)製造堆肥產品使用於玫瑰栽培現況。 |
![]() |
液化澱粉芽孢桿菌菌種(TCB428)製造堆肥產品使用於葡萄栽培現況。 |